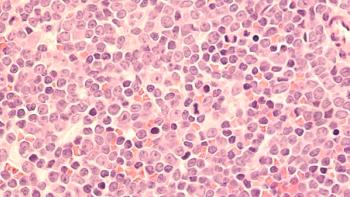

With advancements happening at unprecedented rates, these are the cell and gene therapy companies and pipelines we’re keeping a close eye on.

With advancements happening at unprecedented rates, these are the cell and gene therapy companies and pipelines we’re keeping a close eye on.

The clinical-stage biotech company recently announced the expansion of their phase 1 trial of CYNK-001 in patients with relapsed/refractory acute myeloid leukemia.

Eunice Wang, MD, and Bijal Shah, MD, MS, discussed unmet needs for adult patients with relapsed/refractory ALL and reflect on the current treatment landscape.

The founder and chief executive officer of SQZ Biotech discussed the development and advantages of their proprietary Cell Squeeze technology in creating cell therapies.

Janssen hopes that Vor’s stem cell therapy will allow their bispecific antibody to be better-tolerated.

Bijal Shah, MD, MS, and Eunice Wang, MD, discussed the use of clinical endpoints like CR, CRi, and CRh as they relate to the ZUMA-3 trial of CAR T cell therapy.

Adam Sperling, MD, PhD, from the Dana-Farber Cancer Institute, and an instructor in medicine at Harvard Medical School, discussed managing CAR T-cell therapy–related toxicities in multiple myeloma.

The CEO of Avamab Pharma discussed how funding and research changes directions.

The hematologist from Moffitt Cancer Center discussed the timing of treatment with chimeric antigen receptor T-cell therapy in patients with acute lymphoblastic leukemia.

Study enrollment has been paused following the development of antibodies in the highest-dosed patient.

Bijal Shah, MD, MS, and Eunice Wang, MD, discuss efficacy results of the ZUMA-3 trial of chimeric antigen receptor (CAR) T-cell therapy for acute lymphocytic leukemia (ALL), and review key safety data.

The co-founder, president, and chief executive officer of Solid Biosciences, whose own son has DMD, discussed promising updates from their phase 1/2 IGNITE-DMD trial.

Abbvie, Biogen, and Pfizer have collaborated to launch the free resource that hosts genetic sequencing data from hundreds of thousands of participants.

A new platform that will measure and track immune response to COVID-19 vaccines has recently launched, with implications for long-term healthcare decisions.

Eunice Wang, MD, and Bijal Shah, MD, MS, discuss the overall study design and patient population of the ZUMA-3 trial of CAR T-cell therapy in adult patients with R/R ALL.

The physician at the Dana-Farber Cancer Institute and instructor in medicine at Harvard Medical School discussed future directions that ide-cel research may take.

The phase 3 VITAL study, which is currently enrolling, will evaluate the investigational cell therapy agent further.

Eunice Wang, MD, and Bijal Shah, MD, MS, discussed the use of MRD status to assess therapeutic response and guide treatment decisions in patients with relapsed/refractory ALL.
Leo I. Gordon, MD, and others discussed second-line treatment of diffuse large B-cell lymphoma.

Eunice Wang, MD and Bijal Shah, MD, MS, discuss novel agents and emerging therapeutic approaches for the treatment of acute lymphoblastic leukemia.

Investigators found that bilaterally treated participants experienced greater improvements in BCVA than unilaterally treated participants.

The director of Clinical Research in Hematologic Malignancies at Levine Cancer Institute discussed overall response rate and stringent complete responses in the CARTITUDE-1 trial.

The director of Mayo Clinic's Lymphoma Program discussed R/R FL and current treatment options.

The director of the Mario Lemieux Center for Blood Cancers at UPMC Hillman Cancer Center discussed how the meeting sets the foundation for what’s to come in the treatment of multiple myeloma and other hematologic malignancies.

The chief executive officer of FlowMetric discussed the company’s role in supporting the development of novel gene and cell therapies.

Genetically modified oncolytic viruses may provide a new strategy against malignant tumors.

The engineered natural killer cells lack the off-target effects of typical CAR T-cell therapy and similarly lack any concerning safety signals.

The OPTIC phase 1 study showed that the treatment was associated with a significant reduction in treatment burden after 1 injection.

The FDA’s designation follows positive data presented at the 2020 ASH meeting.

The CEO of Avamab Pharma discussed how the field of gene therapy has shifted due to the COVID-19 pandemic.